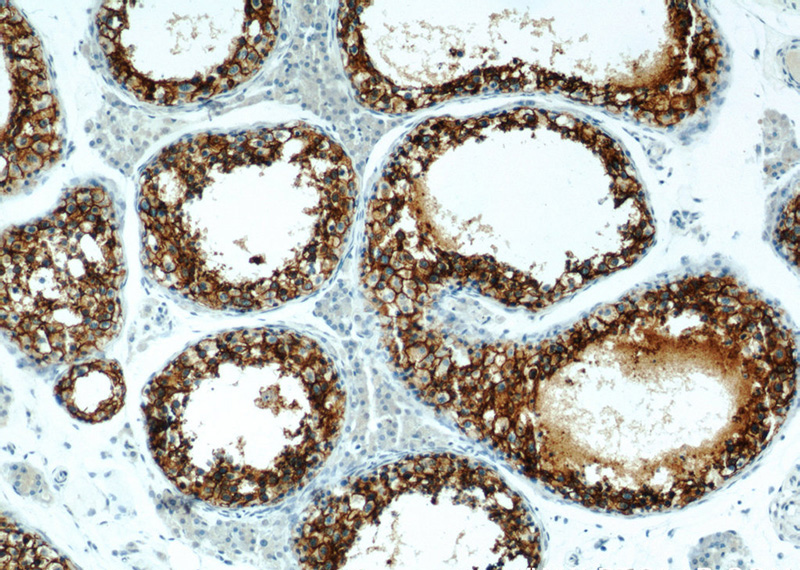

-
Product Name
G3BP1 antibody
- Documents
-
Description
G3BP1 Rabbit Polyclonal antibody. Positive FC detected in HeLa cells. Positive IF detected in HepG2 cells, Ethacrynic acid treated HepG2 cells. Positive IHC detected in human testis tissue, human breast cancer tissue, human skeletal muscle tissue. Positive IP detected in HEK-293 cells. Positive WB detected in A431 cells, C6 cells, HEK-293 cells, HeLa cells, HepG2 cells, human brain tissue, rat brain tissue. Observed molecular weight by Western-blot: 55-60 kDa
-
Tested applications
ELISA, WB, IP, IF, IHC, FC
-
Species reactivity
Human,Mouse,Rat; other species not tested.
-
Alternative names
G3BP antibody; G3BP 1 antibody; G3BP1 antibody; HDH VIII antibody
- Immunogen
-
Isotype
Rabbit IgG
-
Preparation
This antibody was obtained by immunization of G3BP1 recombinant protein (Accession Number: XM_006714750). Purification method: Antigen affinity purified.
-
Clonality
Polyclonal
-
Formulation
PBS with 0.02% sodium azide and 50% glycerol pH 7.3.
-
Storage instructions
Store at -20℃. DO NOT ALIQUOT
-
Applications
Recommended Dilution:
WB: 1:500-1:5000
IP: 1:500-1:5000
IHC: 1:20-1:200
IF: 1:10-1:100
-
Validations

A431 cells were subjected to SDS PAGE followed by western blot with Catalog No:110763(G3BP1 antibody) at dilution of 1:1000

IP Result of anti-G3BP1 (IP:Catalog No:110763, 3ug; Detection:Catalog No:110763 1:1000) with HEK-293 cells lysate 2000ug.
Immunohistochemistry of paraffin-embedded human testis slide using Catalog No:110763(G3BP1 Antibody) at dilution of 1:50

Immunohistochemistry of paraffin-embedded human testis slide using Catalog No:110763(G3BP1 Antibody) at dilution of 1:50

Immunofluorescent analysis of HepG2 cells using Catalog No:110763(G3BP1 Antibody) at dilution of 1:25 and Rhodamine-Goat anti-Rabbit IgG

Immunofluorescent analysis of Ethacrynic acid treated HepG2 cells using Catalog No:110763(G3BP1 Antibody) at dilution of 1:25 and Rhodamine-Goat anti-Rabbit IgG

1X10^6 HeLa cells were stained with 0.2ug G3BP1 antibody (Catalog No:110763, red) and control antibody (blue). Fixed with 90% MeOH blocked with 3% BSA (30 min). Alexa Fluor 488-congugated AffiniPure Goat Anti-Rabbit IgG(H+L) with dilution 1:1000.
-
Background
GAP SH3 Binding Protein 1 (G3BP1), also named as G3BP, is an effector of stress granule (SG) assembly. SG biology plays an important role in the pathophysiology of TDP-43 in ALS and FTLD-U. G3BP1 can be used as a marker of SG. It has been shown to function downstream of Ras and play a role in RNA metabolism, signal transduction, and proliferation. G3BP1 is a ubiquitously expressed protein that localizes to the cytoplasm in proliferating cells and to the nucleus in non-proliferating cells. G3BP1 has recently been implicated in cancer biology.
-
References
- Nishimoto Y, Ito D, Yagi T, Nihei Y, Tsunoda Y, Suzuki N. Characterization of alternative isoforms and inclusion body of the TAR DNA-binding protein-43. The Journal of biological chemistry. 285(1):608-19. 2010.
- there was a problem with your PMID, try again.
- Ito D, Seki M, Tsunoda Y, Uchiyama H, Suzuki N. Nuclear transport impairment of amyotrophic lateral sclerosis-linked mutations in FUS/TLS. Annals of neurology. 69(1):152-62. 2011.
- Dammer EB, Fallini C, Gozal YM. Coaggregation of RNA-binding proteins in a model of TDP-43 proteinopathy with selective RGG motif methylation and a role for RRM1 ubiquitination. PloS one. 7(6):e38658. 2012.
- Nihei Y, Ito D, Suzuki N. Roles of ataxin-2 in pathological cascades mediated by TAR DNA-binding protein 43 (TDP-43) and Fused in Sarcoma (FUS). The Journal of biological chemistry. 287(49):41310-23. 2012.
- Baron DM, Kaushansky LJ, Ward CL. Amyotrophic lateral sclerosis-linked FUS/TLS alters stress granule assembly and dynamics. Molecular neurodegeneration. 8:30. 2013.
- Yamakawa M, Ito D, Honda T. Characterization of the dipeptide repeat protein in the molecular pathogenesis of c9FTD/ALS. Human molecular genetics. 24(6):1630-45. 2015.
- Tao Z, Wang H, Xia Q. Nucleolar stress and impaired stress granule formation contribute to C9orf72 RAN translation-induced cytotoxicity. Human molecular genetics. 24(9):2426-41. 2015.
Related Products / Services
Please note: All products are "FOR RESEARCH USE ONLY AND ARE NOT INTENDED FOR DIAGNOSTIC OR THERAPEUTIC USE"
